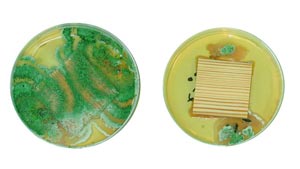
830029.jpg

Wysoka jakość powłok lakierowych zapewnia niemal całkowity brak uszkodzeń okien drewnianych
Systemy trójwarstwowe, ze względu na rzekomo mniejsze koszty, zwracają coraz większą uwagę projektantów okien. Odpowiednie testy pokazują jednak, że wyłącznie znane już systemy czterowarstwowe mogą zapewnić jakość, do której przywykliśmy.
Dla uniknięcia reklamacji i zagwarantowania długiego okresu użytkowania oraz utrzymania stałych wymiarów drewnianych elementów konstrukcyjnych, muszą zostać opracowane i zastosowane specjalne materiały powlekające. Takie, które wykazują dobrą wodoodporność, przyczepność w warunkach dużej wilgotności oraz długotrwałą elastyczność. Materiały, które będą szczególnie chronić okno przed wilgocią w miejscach najbardziej narażonych czyli obszarach krawędzi oraz połączeń wpustowych.
Reklamowane obecnie przez niektórych dostawców systemy trójwarstwowe, jako grupy produktów zoptymalizowane cenowo, niższą cenę uzyskują często kosztem jakości. Dlatego eksperci z firmy Remmers nie mają dobrego zdania na temat upowszechnianej praktyki pomijania jednego lub kilku kroków w procesie aplikacji i koncentrują się, tak jak wcześniej, na systemach czterowarstwowych. Mając to na uwadze, producent lakierów do okien drewnianych poddał systemy czterowarstwowe testom na oddziaływania biologiczne w urzędzie badania materiałów w Eberswalde. Raporty instytutu z testów dokumentują „skuteczność ochrony przed sinizną drewna” a także „skuteczność ochrony przed gniciem (grzybami rozkładającymi drewno)” już przy 80 do 120 ml/m2 naniesionego środka ochrony drewna Induline SW-900 o strukturze czterowarstwowej, podczas gdy przyznawany przez Instytut RAL znak jakości wymaga naniesienia 160 do 200 ml/m2 środka impregnującego.

Przy impregnowaniu metodą malowania przez polewanie, zanurzanie bądź w tunelu natryskowym może i tak być naniesione maksymalnie tylko ok. 100 ml/m2 w jednej operacji. Wytworzenie wysokiej jakości produktów wymaga zatem tylko jednego kroku w procesie przy odpowiedniej skuteczności ochrony, co pozwala zaoszczędzić czas i pieniądze. Remmers zlecił jednocześnie testy bez osobnego impregnatu. Przy zastosowaniu znanego gruntu Induline GW-306 połączonego z lazurującą, jak również kryjącą powłoką pośrednią oraz powłoką końcową, również zachowana jest ochrona przed sinizną oraz gniciem drewna zgodnie z normami EN 152.1 i EN 113. Mimo to systemy powłok, które zawierają również impregnaty, przedłużają znacząco żywotność drewnianych okien. Wrażliwe krawędzie oraz połączenia wpustowe będą właśnie w ten sposób dodatkowo chronione przed wnikaniem wilgoci. Generalnie, staranny dobór surowców stanowi ważny warunek długotrwałego zachowania jakości drewnianych okien. Zarówno ilość, jak i jakość środka wiążącego decydują w znacznym stopniu o jakości lakieru a zarazem także o trwałości całej powierzchni. Dlatego szczególnie ważny jest udział wysokiej jakości spoiw poliuretanowego oraz akrylowego. Ten pierwszy nadaje powłokom nadzwyczaj długotrwałą sprężystość. Obecnie stosowane akryle samosieciujące zapewniają natomiast wczesną wodoodporność oraz przyczepność w warunkach dużej wilgotności. Nowoczesna technologia środków wiążących prowadzi do optymalizacji właściwości lakierów oraz powłok przeświecających (lazurów) i umożliwia uzyskanie trwałych powierzchni. Remmers dąży do uzyskania tych właściwości poprzez stosowanie powłok końcowych takich jak Induline LW-700 oraz DW-601.
Tłumaczenie z „Besser Lackieren!”
Michał Bedyk
nr 2/2010, str. 12






